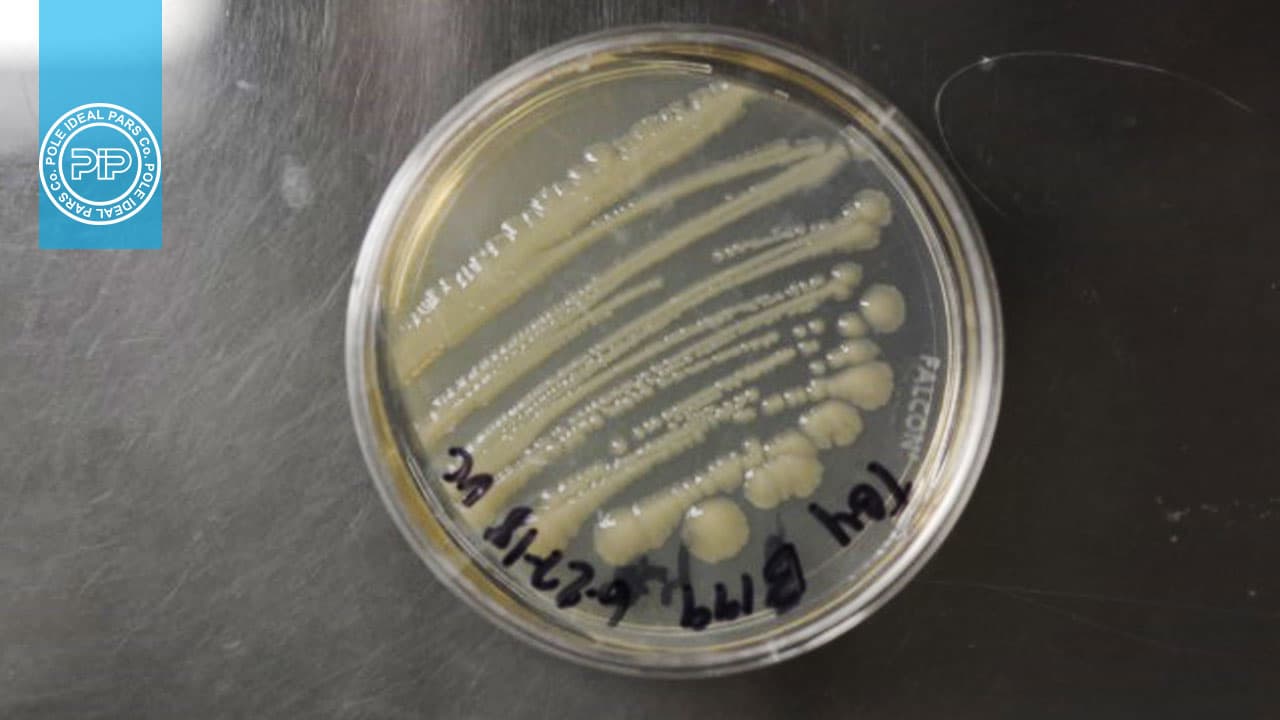
کلبسیلا اکسی توکا مروری بر ویژگیهای پاتوژنتیک و تشخیص آزمایشگاهی
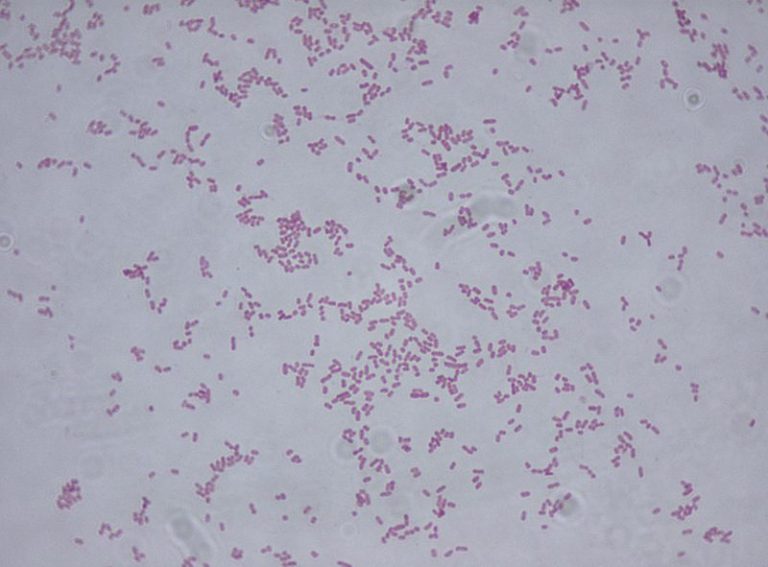
What is the Difference Between Klebsiella Oxytoca and Klebsiella

Klebsiella oxytoca ist ein gram-negatives, stäbchenförmiges Bakterium.
Etymologie
Diese Bakterien gehören zur Familie der Enterobacteriaceae. Benannt wurden sie nach dem ostpreußischen Bakteriologen Edwin Klebs. Das feminine Adjektiv oxytoka bedeutet analog zum Geburtshormon Oxytocin (von altgriechisch ὠκύς ōkys, deutsch ‚schnell‘, und altgriechisch τόκος tokos, deutsch ‚Geburt‘) wie okytokos „schnell gebärend“ oder „schnelle Geburt“. Infektionen der Mutter führen zur Geburtsbeschleunigung oder auch zu Frühgeburten. Infizierte frühgeborene Säuglinge weisen eine erhöhte Sterblichkeit auf.
Erscheinungsbild
Die Bakterien zeigen keine aktive Bewegung und sind von einer Polysaccharidkapsel (Glykokalyx) umgeben. Die Kolonien von K. oxytoca sind gewölbt und bilden nach einer Inkubation über Nacht bei 30 oder 37 °C einen Durchmesser von 3–4 mm.
Wachstum und Stoffwechsel
Der Stoffwechsel unter Sauerstoffausschluss, also unter anoxischen Bedingungen, beruht auf der 2,3-Butandiol-Gärung. Der Voges-Proskauer-Test verläuft also positiv. Wachstum zeigt die Art, je nach untersuchten Stamm, bis 41,5 oder 44,5 °C. Bei 5 °C findet kein Wachstum statt. Klebsiella oxytoca kann man durch den Indol-Test von einigen anderen Klebsiella-Arten unterscheiden. So fällt der Test bei Klebsiella oxytoca positiv aus, bei z. B. Klebsiella pneumoniae hingegen negativ.
Hospitalismuskeim
Antibiotika-resistente Klebsiellae oxytocae können über Waschmaschinen verbreitet werden. Das haben Hygieniker der Universität Bonn für ein Kinderkrankenhaus nachgewiesen, in dem mehrfach ein Klebsiella-oxytoca-Typ auf Neugeborene übertragen wurde. Infektionsquelle war eine handelsübliche Waschmaschine, in der Kleidungsstücke der Neugeborenen gewaschen wurden. Auf der Neugeborenen-Station eines Kinderkrankenhauses in Deutschland wurden bei routinemäßigen Hygiene-Screenings vermehrt antibiotikaresistente Klebsiellae oxytocae festgestellt, berichtet die Universität Bonn. Das Bakterium kann bekanntlich zu Magen-Darm- und zu Atemwegsinfektionen sowie im schlimmsten Fall zur Sepsis führen.
Klebsiella oxytoca ist seit 2006 als Auslöser der antibiotika-assoziierten hämorrhagischen Kolitis bekannt. Neben seinem Vorkommen im Darm von Gesunden ist das fakultativ anaerobes gramnegative Stäbchen auch Erreger nosokomialer Infektionen. In über 95 % besitzt der Keim eine Betalaktamaseaktivität. Im Gegensatz zur Clostridien-Enteritis, die insbesondere das linksseitige Kolon betrifft, besteht hier eine hämorrhagische Entzündung vorwiegend des rechtsseitigen Kolons. Eine Sepsis durch K. oxytoca nach interventioneller ERCP bei Patienten mit einem Malignom der Gallenwege wurde im Rahmen einer österreichischen Fallstudie als Einzelfall beschrieben.
Ökologie
Klebsiella oxytoca ist im Verdauungstrakt von Menschen und Tieren vorhanden. Es wurde auch in Pflanzen und in aquatischen Umgebungen isoliert. Klebsiella oxytoca bilden eine mutualistische Beziehung mit der Stubenfliege (Musca domestica). Das Bakterium lebt auf dem Eigelege der Fliege und hat eine mykotoxische Wirkung, was den Fliegenlarven zugutekommt, die mit den Pilzen um Nährstoffe konkurrieren. Das Bakterium wurde hinsichtlich seines Nutzens bei der industriellen Produktion von Ethanol untersucht.
Krankheitserreger
Infektionen mit Klebsiella oxytoca können zu einer Colitis und zur Sepsis führen.
Literatur
- George M. Garrity (Hrsg.): Bergey’s Manual of Systematic Bacteriology. 2. Auflage, Band 2: The Proteobacteria. Part B: The Gammaproteobacteria. Springer, New York 2005, ISBN 0-387-95040-0
Einzelnachweise